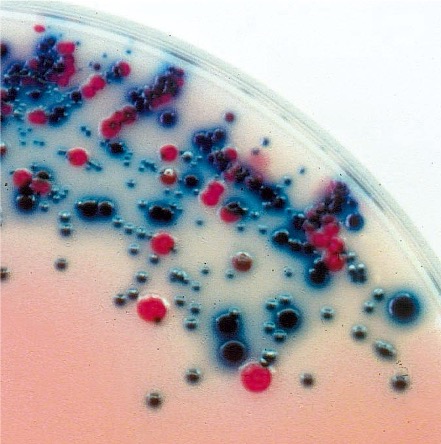

Health and life safety have always been our top priorities.
With our expertise and innovative approach, we have successfully developed new diagnostic reagents across various fields, including biochemistry, biomedical science, pharmaceutical science, and related scientific disciplines.
We remain committed to advancing our research and development efforts, contributing to the well-being of society through the continuous development of cutting-edge diagnostic reagents.
Our product lineup includes: